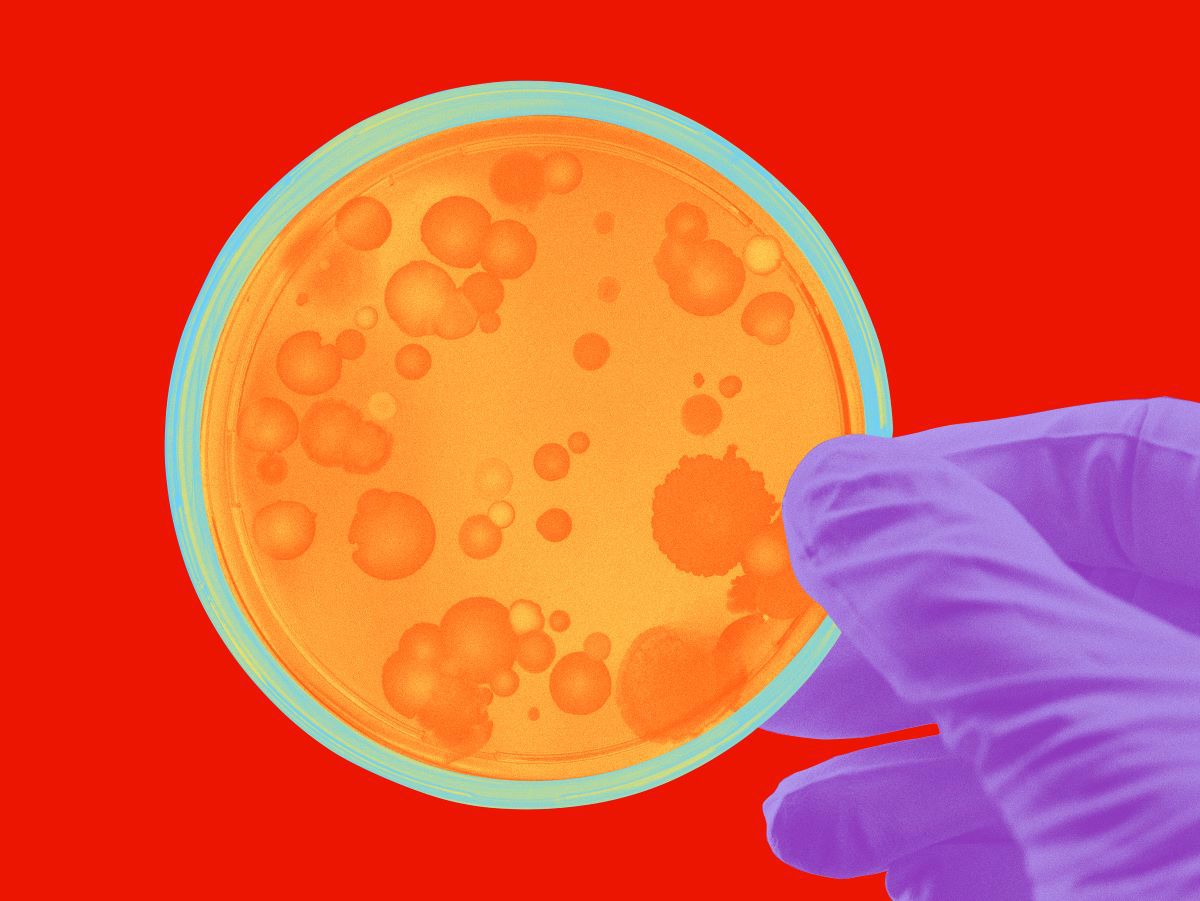

Johnson & Johnson Innovative Medicine has been in Portugal for 40 years, where it currently has 47 clinical trials underway. The country has become strategic for the development of new therapies and was chosen to host Johnson & Johnson's new Global Medical Safety Hub, a centre that guarantees the high standards of product safety and efficacy, generates skilled jobs in Portugal and exports knowledge to other markets.
Johnson & Johnson Innovative Medicine began as a small laboratory in Belgium 132 years ago and has since grown into one of the world's largest pharmaceutical companies. The company, which invests more than 15 billion dollars annually in research and development (R&D), has developed 80 medicines, 21 of which are considered essential by the World Health Organisation (WHO).
Oncology, haematology, neuroscience, immunology, pulmonary arterial hypertension and infectious diseases are some of the areas in which the company is working. In oncology, for example, Roche has invested in gene and cell therapies such as immunotherapies and CAR T-cell therapies, which have shown promising results in several types of cancer.